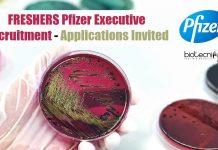
FRESHERS Pfizer Executive Recruitment – Applications Invited Freshers Pfizer Executive Recruitment

Phase I Clinical Study For Covaxin Shows Robust Immune Response : Bharat Biotech
Covaxin Phase I Trial Report Shows Robust Immunological Response
The early results of Phase I studies of Covaxin, the COVID-19 vaccine, indigenously produced by Bharat...
Karnataka May Require 1.47 Lakh Vaccination Personnel To Kick-start COVID-19 Vaccination Drive
COVID-19 vaccination drive: Karnataka may require 1.47 lakh staffs
Karnataka may need at least 1.47 lakh vaccination personnel to kick-start the arduous COVID-19 vaccination drive....
FREE Webinar : Exclusive Masterclass On CADD – Computer Aided Drug Design – Must...
Computer-Aided Drug Design CADD FREE Webinar
FREE MasterClass on CADD For All
Hello there!
The whole world is talking about new drugs, vaccines and now more than...
COVID-19 Research Consortium SRF Recruitment at MKU
Madurai Kamaraj University SRF - Biophysics/ Biotech/ Life Sciences
Madurai Kamaraj University SRF - Biophysics/ Biotech/ Life Sciences. Senior Research Fellow Job Opening at Madurai...
NIPGR JRF & PA Jobs – Short-Term Research Fellowships Recruitment
NIPGR JRF & PA Jobs - Short-Term Research Fellowships Recruitment
NIPGR JRF & PA Jobs - Short-Term Research Fellowships Recruitment. Life Science/ Biochemistry/Biotechnology/Molecular Biology/Botany Jobs....
Life Sciences Drug Discovery Project Recruitment at JNU
Life Sciences Drug Discovery Project Recruitment at JNU
Life Sciences Drug Discovery Project Recruitment at JNU. Life Science Research Associate Jobs. Candidates can apply for...
PGIMER Biotech & Life Science Research With Rs. 47,000 pm Salary
PGIMER Biotech & Life Science Research With Rs. 47,000 pm Salary
PGIMER Biotech & Life Science Research With Rs. 47,000 pm Salary. MSc/PhD Biotechnology and...
Parexel Hiring Life Sciences For Medical Writer Vacancy – Applications Invited
Parexel Hiring Life Sciences For Medical Writer Vacancy
Parexel Medical Writing - Life Sciences/ Microbiology/ Biochem/ Biotech. Parexel Hiring Life Sciences For Medical Writer Vacancy....
NCCS Pune Research Personnel Recruitment – Applications Invited
NCCS Pune Research Personnel Recruitment - Applications Invited
NCCS Pune Research Personnel Recruitment - Applications Invited. Biological Science & Life sciences jobs for msc /...
AIIMS Delhi Scientist Job With Rs. 56,000 pm Salary – Applications Invited
AIIMS Delhi Scientist Job With Rs. 56,000 pm Salary - Applications Invited
AIIMS Delhi Scientist Job With Rs. 56,000 pm Salary - Applications Invited. Scientist...
CDFD Research Associate Post With Rs. 47,000 pm Salary Recruitment
CDFD Research Associate Post With Rs. 47,000 pm Salary Recruitment
CDFD Research Associate Post With Rs. 47,000 pm Salary Recruitment. PhD biotechnology, cell biology and...
IIT Delhi BIRAC Funded Biotech & Biochem Junior Research Fellow Job
IIT Delhi Biotech & Biochem Junior Research Fellow Job
IIT Delhi Biotech & Biochem Junior Research Fellow Job. MSc/MTech Biotech & Biochemistry Junior Research Fellow...
Presidency University Project Assistant Job For Botany / Microbiology & Life Science
Presidency University Project Assistant Vacancy Available
Presidency University Project Assistant Vacancy Available. Presidency University is hiring msc candidates for project assistant post. Interested and eligible...
FRESHERS Pfizer Executive Recruitment – Applications Invited
Freshers Pfizer Executive Recruitment - Applications Invited
Freshers Pfizer Executive Recruitment - Applications Invited. Pfizer is hiring MSc Microbiology candidates for Executive-Microbiology vacancy. Interested and...
Madurai Kamaraj University Junior Research Fellow Job Opening
MKU Plant Science Job - Junior Research Fellow Post
MKU Plant Science Job - Junior Research Fellow Post. Madurai Kamaraj University is recruiting for JRF...